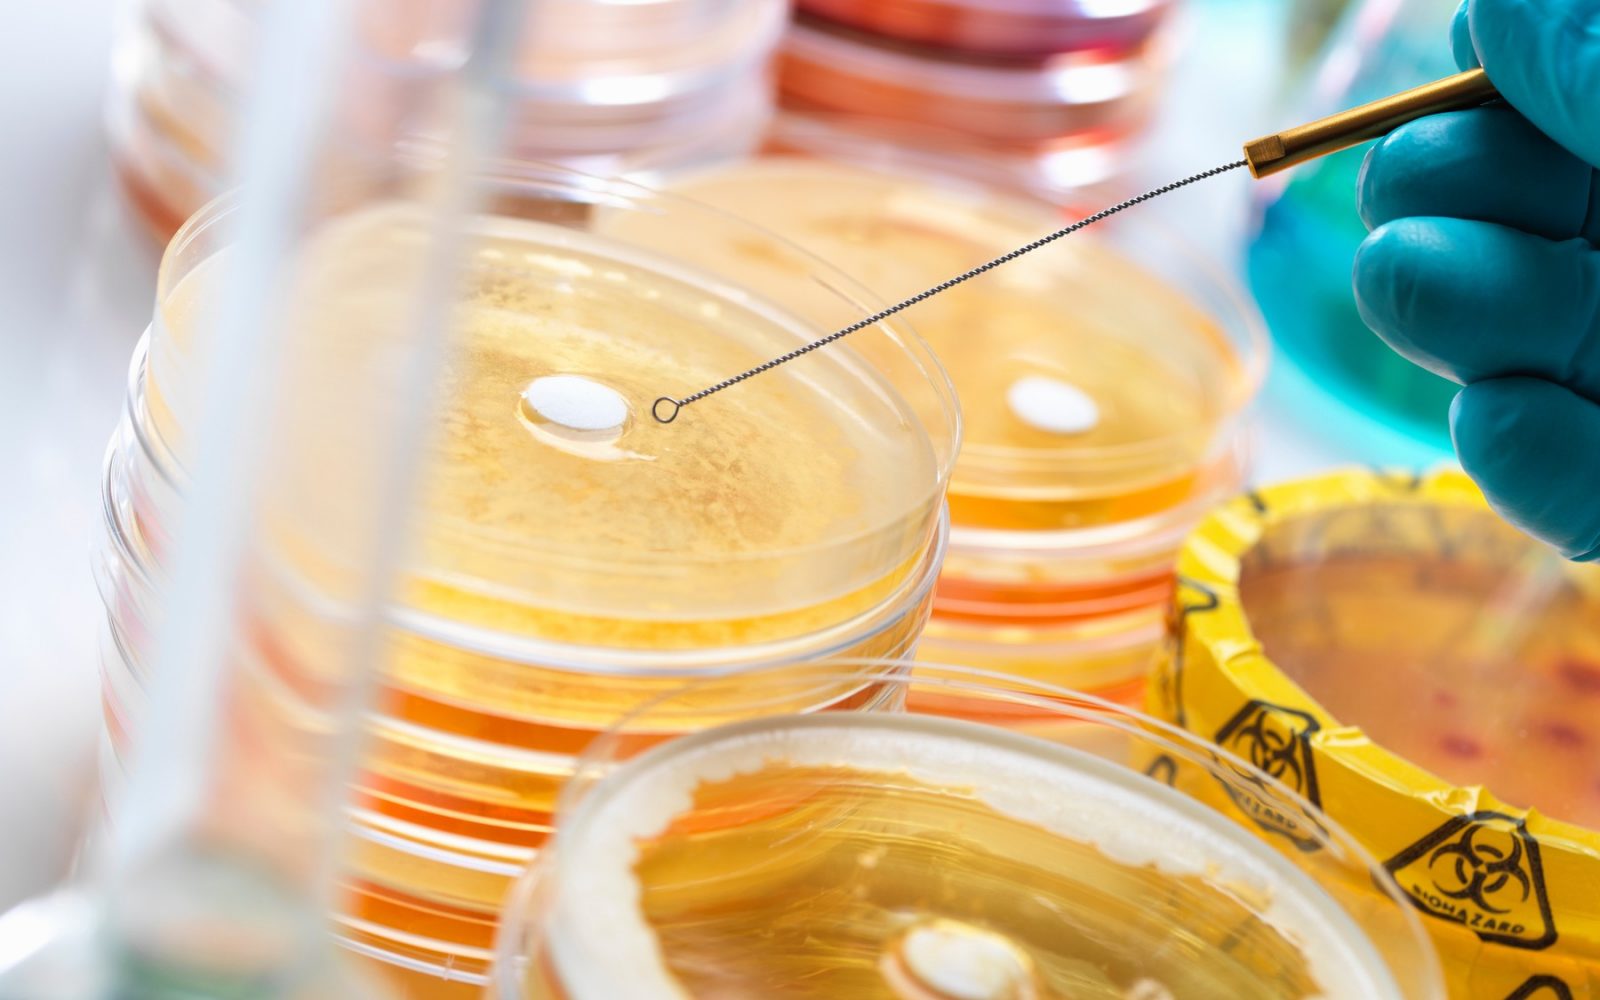
Petrijevke z laboratorijskim testiranjem za odpornost bakterij proti antibiotikom.

Antibiotiki so neprecenljivo zdravilo sodobne medicine, vendar njihova nepremišljena uporaba povzroča tihi kaos. “V EU zaradi odpornosti bakterij na antibiotike letno umre kar 35.000 ljudi – to je več življenj kot jih skupaj vzamejo gripa, tuberkuloza in HIV/AIDS,” poroča Nacionalni inštitut za javno zdravje (NIJZ).
Zakaj se to dogaja
Bakterije, ki se jih neustrezno zdravi, razvijejo odpornost na antibiotike, zaradi tega postanejo običajne okužbe smrtonosne. Odpornost na antibiotike postaja ena najresnejših groženj sodobne medicine, ki nas lahko vrne v čas pred odkritjem antibiotikov. Antibiotična odpornost nastane, ko bakterije postanejo odporne na delovanje antibiotikov. To pomeni, da zdravila, ki so prej uspešno zdravila okužbe, postanejo neučinkovita.
Na primer: Okužba sečil, ki jo pogosto povzročajo bakterije Escherichia coli, se običajno zdravi z antibiotiki, kot je amoksicilin. Če pa bakterije razvijejo odpornost na amoksicilin, zdravljenje s tem antibiotikom ne bo več učinkovito, okužba pa lahko napreduje in povzroči resne zaplete, kot so ledvične okužbe ali sepso. Razlog? Prekomerna in napačna uporaba antibiotikov, ki omogoča bakterijam, da razvijejo mehanizme za preživetje.
Antibiotiki so dragoceni zavezniki, a le, ko jih uporabljamo pravilno.
Šokantna dejstva
- V EU se letno zgodi 4,3 milijona bolnišničnih okužb, od katerih jih velik del povzročijo odporne bakterije.
- Vsak tretji mikroorganizem, ki povzroča bolnišnične okužbe, je bakterija.
- Odpornost bakterij povzroča daljše hospitalizacije, več zapletov in višje stroške zdravljenja.
Zakaj pride do tega
Do napačne uporabe antibiotikov pogosto prihaja zaradi nezavedanja o njihovem delovanju in posledicah. Antibiotiki so učinkoviti le proti bakterijskim okužbam, ne pa tudi proti virusnim, kot so prehlad, gripa ali COVID-19. Ko ljudje prekinejo zdravljenje, ko se počutijo bolje, omogočijo bakterijam, da preživijo in razvijejo odpornost na antibiotike, kar vodi v težje obvladovanje okužb v prihodnosti. Poleg tega deljenje antibiotikov, ki so prilagojeni določeni vrsti bakterij, povečuje tveganje za neučinkovito zdravljenje, saj se lahko uporabljajo proti napačnim vrstam bakterij, kar še dodatno spodbuja razvoj odpornosti.
Ko antibiotiki ne delujejo več:
- Običajne okužbe, kot so pljučnice in sečne okužbe, postanejo smrtonosne.
- Moderne medicinske prakse, kot so operacije in kemoterapija, postanejo zelo tveganje zaradi povečane ranljivosti bolnikov.
Vaša odgovornost je, da jih ne zlorabljate.
Kako lahko preprečimo katastrofo?
- Uporabljajte antibiotike le na zdravniški recept. Ne jemljite jih za prehlad ali gripo.
- Zaključite predpisano zdravljenje. Ne prenehajte jemati antibiotikov, tudi če se počutite bolje.
- Ne delite antibiotikov z drugimi.
- Skrbite za higieno: Pravilno umivanje rok zmanjša prenos okužb.
- Cepljenje: Preprečite bolezni, ki jih lahko obvladamo s cepljenjem.
Evropska unija si prizadeva za obvladovanje protimikrobne odpornosti z integriranim pristopom „Eno zdravje“ (One Health). Projekti, kot je EU-JAMRAI, povezujejo strokovnjake, da bi zmanjšali uporabo antibiotikov in izboljšali preprečevanje okužb.